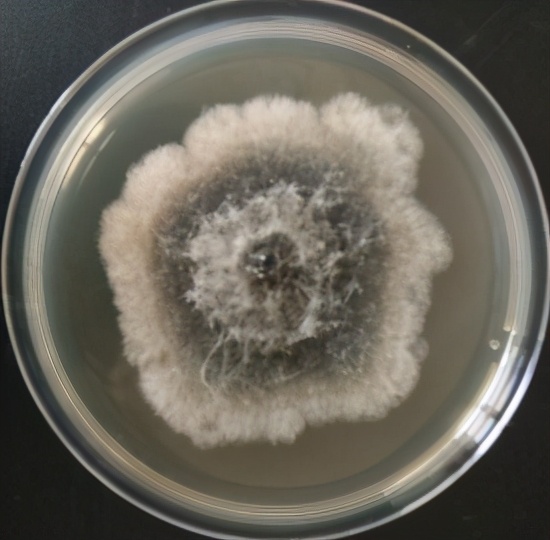
葡萄溃疡病的防治方法,葡萄溃疡病与白腐病有什么区别

葡萄溃疡病是一种严重的葡萄病害,在我国葡萄生产区普遍存在,主要由葡萄座腔菌属(Botryosphaeria sp.)引发。会导致葡萄枝干或果实组织坏死,更严重的还会引起根腐,致使整株枯死。到目前为止,已发现葡萄座腔菌科(Botryosphaeriaceae)的15个种能引起溃疡病,并日益加重。其中,B.dothidea在浙江、江苏、广西、山西、北京等地被发现并造成减产30-50%。
葡萄溃疡病的症状
葡萄溃疡病主要危害果穗和枝条。危害果穗,主要在果实转色期出现症状,首先在穗轴出现褐色、水浸状病斑,湿度大时迅速向四周扩展,使整个小穗轴变褐坏死,发病后期葡萄粒易脱落。有时果粒不脱落,逐渐干缩(图1)。枝条受害,当年生枝条上出现梭型病斑,病斑上着生黑色小点,横切维管束变褐。

图1 葡萄溃疡病症状

图1 葡萄溃疡病症状
病原
我国的葡萄溃疡病由多种病原菌引发,已知引起世界范围内葡萄溃疡的病原菌有20多种,危害我国的溃疡病菌主要有Botryosphaeria dothieda、Neofusicoccum parvum、Lasiodiplodia theobromae、Diplodia seriata等。但主要是葡萄座腔菌属(Botryosphaeria sp.),该菌菌落生长为近圆形菌落,边缘较整齐,菌落正面初为白色,后渐变为灰白色,灰褐色,最后变为灰黑色气生浓密菌丝,呈絮状隆起。背面初期淡黄色,中央逐渐变为暗绿色,后期为墨绿色,分生孢子梭形,大小为17.75~20.56 µm×4.89~7.07 µm(图2)。
图2 病原菌形态

图2 病原菌形态

图2 病原菌形态
发病规律
葡萄溃疡病菌可在发病枝条,病果上越冬,通过气流或雨水传播,病菌主要通过修枝、日灼、动物或昆虫留下的伤口、自然孔口侵入,病原菌通过伤口侵入时,可导致严重发病,侵染成功率高且致病性强。经自然孔口侵入时,侵染力大大削弱且潜育期变长。树势弱的葡萄易感病。
主要防治方法
1选用抗病品种
优先选择抗病品种可以减少损失。如高抗品种有美人指,藤稔等。也可选择抗病品种如巨峰、玫瑰香、红地球等。
2做好清园工作,降低菌源数量
修剪后及时清除田间发病枝条、果穗,带出园外集中销毁,葡萄生长季一旦发现有枝条或果实出现溃疡病变,一定要立即剪除,用氟硅唑涂抹伤口。果穗发病,解袋后剪除发病部位,并用异霉唑处理伤口,药液干后换新袋子套上。在果园中配合施加保护树木的石硫合剂、波尔多液等药剂,会达到更好的效果。
3加强栽培管理
前期预防工作要到位,加强田间管理,合理肥水,合理修枝,提高树势,增强植株抗病能力,并严格控制产量。控制葡萄架夜幕,保持良好的通风透光性。棚室栽培的要及时覆盖薄膜,避免葡萄植株淋雨。
4药剂防治
开花前、果实生长期、套袋前及转色成熟期是防治的关键时期。套袋前喷施25%嘧菌酯2000倍液和40%苯醚甲环唑4000-5000倍液,或24%甲硫己唑醇1000倍液,25%丙环唑乳油4000倍液进行喷雾防治。发病枝条及时剪除,剪口用40%氟硅唑乳油8000倍液处理剪口或发病部位。对枝干病斑进行刮治,使用50%福美双+有机硅涂抹,使用50%福美双30-60倍液+有机硅进行枝干喷雾。发病果穗及时剪除并用50%异霉唑乳油3000倍液处理伤口。
山东省葡萄研究院尹向田、王咏梅、宫磊